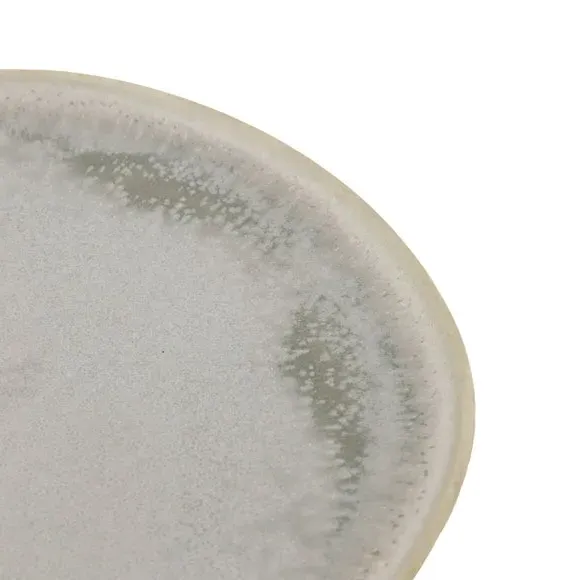

The side plates offer handcrafted charm with their wobbly pebble shapes and soft grey reactive glaze. Each plate features unique variations from the firing process, while the glazed ceramic construction provides durability for daily use. The compact design suits nibbles, desserts, and sweet treats, and the coordinating finish complements other tableware pieces.
* Pack of 4* Coordinating items available* Lovely glazed finish Brighten up snack time with Cedar and Sage's Pack of 4 Pebble Glaze Dove Side Plates. Their charming wobbly shapes and soft grey glaze bring a relaxed, handcrafted vibe that's anything but ordinary. Fired with a reactive glaze, each one's got its own unique twist. From nibbles to desserts, they're the perfect excuse to show off and plate up your favourite sweet treats. Whether it's a chilled brunch or a full on dinner party, these plates know how to mingle.
Similar items powered by AI
More from Dunelm
Show MoreRefine your search
10,000+ curated items listed